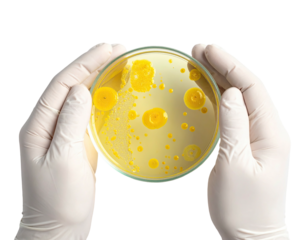
Petri dish with yellow colonies held by gloved hands

- Home >
- Stock PNGs >
- Hands Holding Transparent Word Study for Education Concept
Hands Holding Transparent Word Study for Education Concept PNG

Hands of four individuals hold large colorful letters making the word 'study' on a transparent background. This creative imagery is ideal for use in educational materials, brochures, online courses, school promotions, or study guides engaging with themes of learning, teamwork, and collaboration.
Credit Photo
If you would like to credit the Photo, here are some ways you can do so
Text Link
png Link
<span class="text-link">
<span>
<a target="_blank" href=https://pikwizard.com/png/hands-holding-transparent-word-study-for-education-concept/b9e5940704678322d578f5fa6b483fd4/>PikWizard</a>
</span>
</span>
<span class="image-link">
<span
style="margin: 0 0 20px 0; display: inline-block; vertical-align: middle; width: 100%;"
>
<a
target="_blank"
href="https://pikwizard.com/png/hands-holding-transparent-word-study-for-education-concept/b9e5940704678322d578f5fa6b483fd4/"
style="text-decoration: none; font-size: 10px; margin: 0;"
>
<img src="https://pikwizard.com/pw/medium/b9e5940704678322d578f5fa6b483fd4.png" style="margin: 0; width: 100%;" alt="" />
<p style="font-size: 12px; margin: 0;">PikWizard</p>
</a>
</span>
</span>
Free (free of charge)
Free for personal and commercial use.
Author: Awesome Content
Similar Free PNG Images With Transparent Background
Loading...